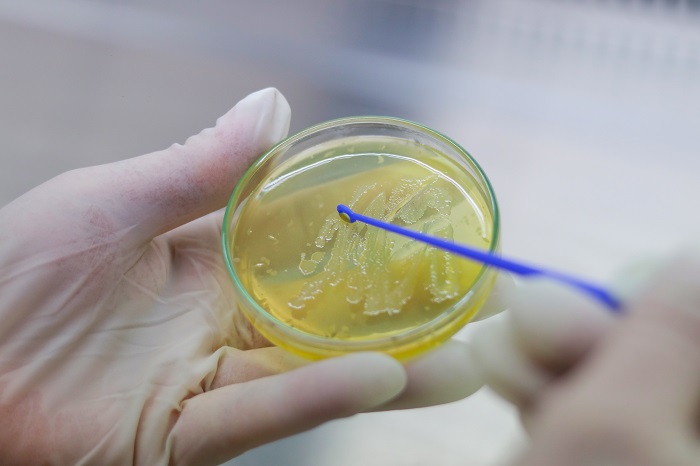

Tibbi-sosial araşdırmalar və elmi-tədqiqat işlərinin planlaşdırılması şöbəsi
Elmi bölmələr
Son xəbərlər
-

"FEBRİL QICOLMALAR"
03.03.2021 -

"İDRAR YOLU ENFEKSİYONU"
24.02.2021 -

"HENOCH-SCHÖNLEİN PURPURA"(HSP)
20.02.2021 -

"Prematür Retinopatiyaları" adlı seminar
19.02.2021 -

"Tibb bacısının əməliyyatdan sonra xəstəyə nəzarəti"
19.02.2021 -

ETPİ və META-nın birgə təşkil etdiyi Pediatrik Konfrans
11.02.2021 -

"Yeni doğulmuşlarda sarılıq" seminarı
04.02.2021 -

"Pediatrik resüsitasiyonda güncel yaklaşımlar" vebinarı keçirilmişdir.
04.02.2021 -

"Bos değerlendirmesi ve merkezi sinir sistemi enfeksiyonları" vebinarı
01.02.2021 -

ETPİ-nun direktoru Fəxri Fərmanla Təltif olundu.
30.12.2020
